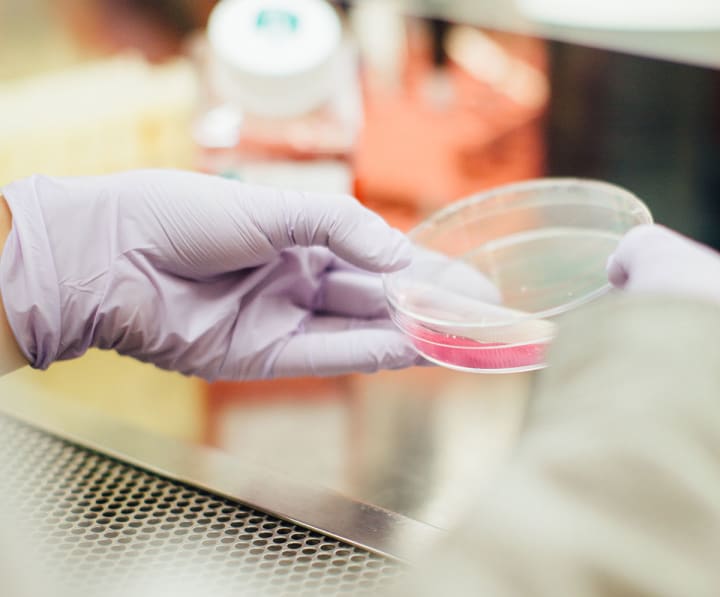

Must Have Health Care Benefits
These health care essentials are must haves in your policy.

Perhaps the most contentious, expensive and complicated issue in modern American society is the issue of healthcare. Who pays for it, how much, what’s covered who needs to be covered, what if any penalties should an individual face for not having coverage, what if any penalties should a company face for not providing health insurance are all topics of debate if not legally practically. Since the Affordable Care Act (ACA), aka Obamacare went into effect in 2010, the entire health insurance, and by extension medical industry has been in a constant state of flux.
All of a sudden individuals no longer had a choice to NOT carry health insurance, they had to or they’d be penalized by the IRS. Companies by the same token were also now forced to provide health coverage to their teams if they had a minimum of at least 50-full-time employees. Of course the politics around this issue are hot, and the complexities impossibly deep to try and unravel in a single blog post. Yet one area that as it stands now (with the new administration this may soon change) is of the utmost importance pretty much everyone covered under an ACA plan is what exactly is covered.
Before we list out the 10 must have health care benefits as outlined by the ACA, it’s important to illustrate the distinction between two terms that sound very similar and thus cause many people a great deal of confusion. Essential health care benefits (EHCB) and Minimum essential coverage (MEC). EHCB refers to the items that any qualified health plan must cover, whereas MEC simply refers to what an individual must have (a health plan of some kind) to satisfy the individual mandate thus avoid the penalty tax.
Now that we have clarified the difference between theses like-sounding terms, I’d like to point out one final note before proceeding to the primary focus of this article, the 10 EHCB’s that are mandatory under the ACA. That note is the simple fact that these 10-required coverage items we’re about to share with you are NOT inclusive of everything ACA-compliant plans are required to cover, they are merely ten broad categories under which myriad services and procedures fall. Therefore, for specific questions on coverage on a procedure or service that may fall under one of these categories it’s best to consult your health plan or health plan provider.
Ambulatory Services
All ACA plans are required to provide coverage for some level of ambulatory service. This service is intended to cover doctor office visits and some outpatient procedures like in-office operations and such that do not require a hospital visit. Generally, these services are less expensive to render than those in a hospital.
Emergency Services

Photo by Osman Rana
These are sudden unexpected visits to the emergency room. This ECHB is in place to cover medical events that are random and thus would not generally require pre-approval from the insurance company on whether something is or isn’t specifically covered.
Hospitalization
The ACA mandates plans provide coverage for in-hospital care. Things like major operations or prolonged sickness fall into this broad category.
Maternity and New Born Care

Photo by Daiga Ellaby
Coverage for prenatal and services related to baby delivery are generally covered under the ACA mandates of this category. Post birth treatments are also generally covered as well.
Mental Health and Substance Abuse
One of the more controversial coverages required by the ACA, this category mandates benefits for those who suffer from mental disorders and addictions to substances like painkillers and other drugs. The controversy comes mostly on the second part of this, as many believe addiction is merely a sign of mental weakness and not a medical condition. Some plans limit access to 20-days per year.
Prescription Drugs

One of the big wins for the ACA when it was passed was extending coverage for medications. Since medication is such a huge part of the medical care of many individuals this benefit is often a huge expense for insurers. Expect a lot of variance in coverage limits and amounts from drug to drug. This is definitely one you want to review the details of your plan carefully before proceeding. Sometimes there are multiple drugs that do the same or close to the same thing. Often one of these drugs will be covered by a plan and another won’t or will be covered to a lesser extent. Talk with your insurance provider and doctor when deciding on what prescriptions to take and get the best deal you can for yourself.
Rehabilitation and Rehab Devices
This is another category that carries with it a seemingly endless array of complexities, limitations and exceptions. Do your research on this one. Yet in theory it is there to cover things like rehabbing a joint after a replacement operation.
Lab Services
Photo by Drew Hays
One of the most accurate and common ways to diagnose complex aliments is through lab work. The ACA requires plans to provide a certain level of coverage for these types of diagnostic procedures.
Preventative Services & Chronic Disease Management
Another point of hot contention in the mandated ECHB coverage laid down by the ACA was the chronic disease management, more popularly referred to as the eliminating of the ‘preexisting condition clause’ that was so often used before the laws passing to deny someone coverage based on a disease or disorder previously diagnosed prior to obtaining coverage. Of course preventative services like regular check-ups were commonly covered in full prior to the new law so this was more or less a carryover.
Pediatric Services
Of course the kids need to be taken care of so any provider that is in compliance with the healthcare law is required to provide a level of care for the little guys and girls.



Comments
There are no comments for this story
Be the first to respond and start the conversation.